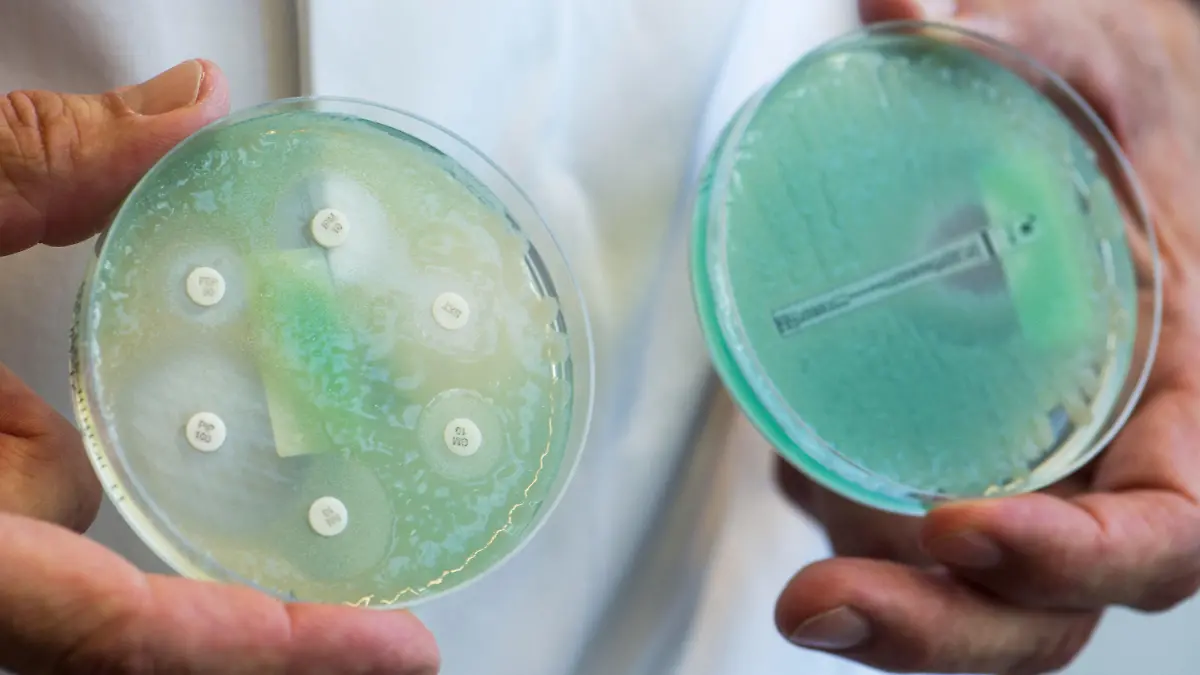

Kommt weltweit im Boden und im Wasser vorGesundheitslexikon: Pseudomonas aeruginosa
Pseudomonas aeruginosa ist ein Bakterium der Ordnung Pseudomonadales. Das Bakterium ist eigentlich in Böden und Pfützen zu Hause, hat sich aber in letzter Zeit auch als Krankenhauskeim mit Mehrfachresistenzen einen traurigen Namen gemacht. Wie kommt es zu dieser schlechten Entwicklung?
Woher kommt Pseudomonas aeruginosa?
Pseudomonas aeruginsoa ist ein Boden- und Pfützenkeim und kann als Zersetzungsexperte in ökologischen Kreisläufen eine wichtige Rolle einnehmen. Der Keim ist in der Rhizosphäre, dem Wurzelreich der Pflanzen, beheimatet. Er lebt häufig in einem symbiotischen Verhältnis mit bestimmten Pflanzenarten und kann für diese eine abwehrstärkende und wachstumsfördernde Wirkung haben. Den wachstumsfördernden Effekt kann er durch eine effektive Aufspaltung von Nährstoffen gewährleisten, welche anschließend von den Pflanzen besser aufgenommen werden. Einen abwehrstärkenden Effekt haben viele Pseudomonaden auf die Pflanzen, indem sie das Wurzelreich mit Fungiziden anreichern. Die Fungizide können schädliche Pilzsorten abwehren und somit vielen Pflanzen helfen.
Warum ist ein Pflanzenkeim plötzlich so gefährlich?
Pseudomonaden sind als Pflanzen- und Bodenkeime nicht ganz ungefährlich. Sie können bei Pflanzen eine zerstörende Wirkung haben. In Bezug auf Menschen gibt es mit Pseudomonas aeruginosa ein großes Problem: Herkömmliche Erreger sind eigentlich wirtsgebunden. Sie können also ohne ihren Wirt nicht oder nur schwer überleben. Oft sind pathogene Keime so sehr auf einen Wirt spezialisiert, dass sie nicht zwischen Menschen und Tieren übertragen werden. Leider gelten diese evolutionären Mechanismen der Spezialisierung nicht für Pseudomonas aeruginosa, da er ein Umweltkeim ist. Dies befähigt ihn nicht nur zum wirtsunabhängigen Überdauern, sondern ganz im Gegenteil auch zu einem vorzüglichen Leben ohne Wirt.
Wieso ist der Keim gerade im Krankenhaus so gefürchtet?
Pseudomonas aeruginosa hat sich als Krankenhauskeim einen Namen gemacht, da er an jedem Schuh, Waschbecken und Dialyse-Gerät problemlos überdauern kann. Natürlich kann er auch über Menschen aus den Krankenhäusern hinaus und in die Krankenhäuser hinein getragen werden. Dazu hat er in den Krankenhäusern eine Reihe von Antibiotika-Resistenzen erworben, durch die er noch schwerer zu bekämpfen ist. Eine Infektion ist für gesunde Menschen ungefährlich, kann aber bei immunsupprimierten Patienten und Patienten mit offenen Wunden zu schweren Komplikationen führen. Die Kombination aus Antibiotika-Resistenzen, weiteren Virulenzfaktoren und ubiquitärem Vorkommen macht diesen Keim so überaus gefährlich.
Aber warum greift denn ein Bodenkeim plötzlich Menschen an?
Mit dem Angreifen ist es so eine Sache: Letzten Endes bestehen alle Pflanzen und Tiere aus den gleichen Bausteinen. Und auch Pseudomonas aeruginosa besteht aus diesen Bausteinen und benötigt sie zum Überleben. Er kann sie im Boden oder in einer Pfütze finden. Genauso gut kann er aber auch das Eisen aus einer offenen Wunde abbauen und eine eitrige Infektion auslösen. Der Keim tut also das, was er am besten kann und das ist das Abbauen von Nährstoffen. Das hierfür verwendete Spektrum an Werkzeugen ist bis heute noch nicht vollständig erforscht.
Wichtiger Hinweis: Dieser Artikel kann einen Besuch beim Arzt nicht ersetzen. Er enthält nur allgemeine Hinweise und darf daher keinesfalls zu einer Selbstdiagnose oder Selbstbehandlung herangezogen werden.